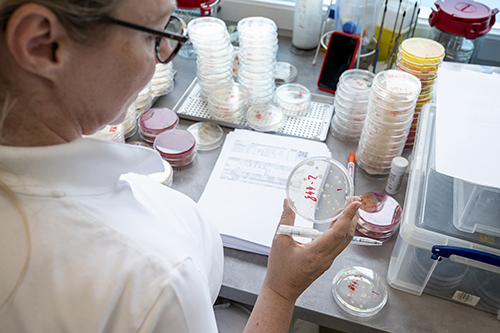

W.H.U. GMBH
Labor für Wasser | Hygiene | Umwelt
Die W.H.U. GmbH ist eine von der Akkreditierung Austria akkreditierte Prüf- und Inspektionsstelle für Wasser, Hygiene und Umweltanalytik.
Prüfungen werden in unserem Labor in Bischofshofen / Land Salzburg durchgeführt.
Prüfungen werden in unserem Labor in Bischofshofen / Land Salzburg durchgeführt.

AKTUELLES
UNSERE FACHGEBIETE
Entdecken Sie, was wir machen


Quicklinks
Haben wir Sie überzeugt?
Rufen Sie uns an und vereinbaren Sie einen Termin:
Sie möchten uns direkt anschreiben?